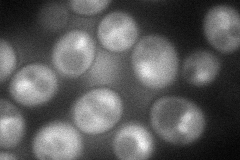
YNL075W

View description
Component of the SSU processome, which is required for pre-18S rRNA processing; interacts with Mpp10p; member of a superfamily of proteins that contain a sigma(70)-like motif and associate with RNAs
Localization:
Intensity:
Fold change:
Significance:
-
C’ GFP library in SD

below threshold15.14 -
N' NOP1pr-GFP in SD
cytosol,nucleolus87.3217 -
N' TEF2pr-mCherry in SD

missing0 -
N' NATIVEpr-GFP in SD

missing0 -
N' TEF2pr-VC and Cyto-VN in SD

#N/A0 -
C’ GFP library in SD+DTT

cytosolN/AN/ANo -
C’ GFP library in SD+H2O2

cytosolN/AN/ANo -
C’ GFP library in Starvation Media

cytosolN/AN/AYes -
C’ GFP library on the background of Pup2-DaMP

below threshold -
C’ GFP library on the background of CCT mutant

below thresholdN/AN/ANo
